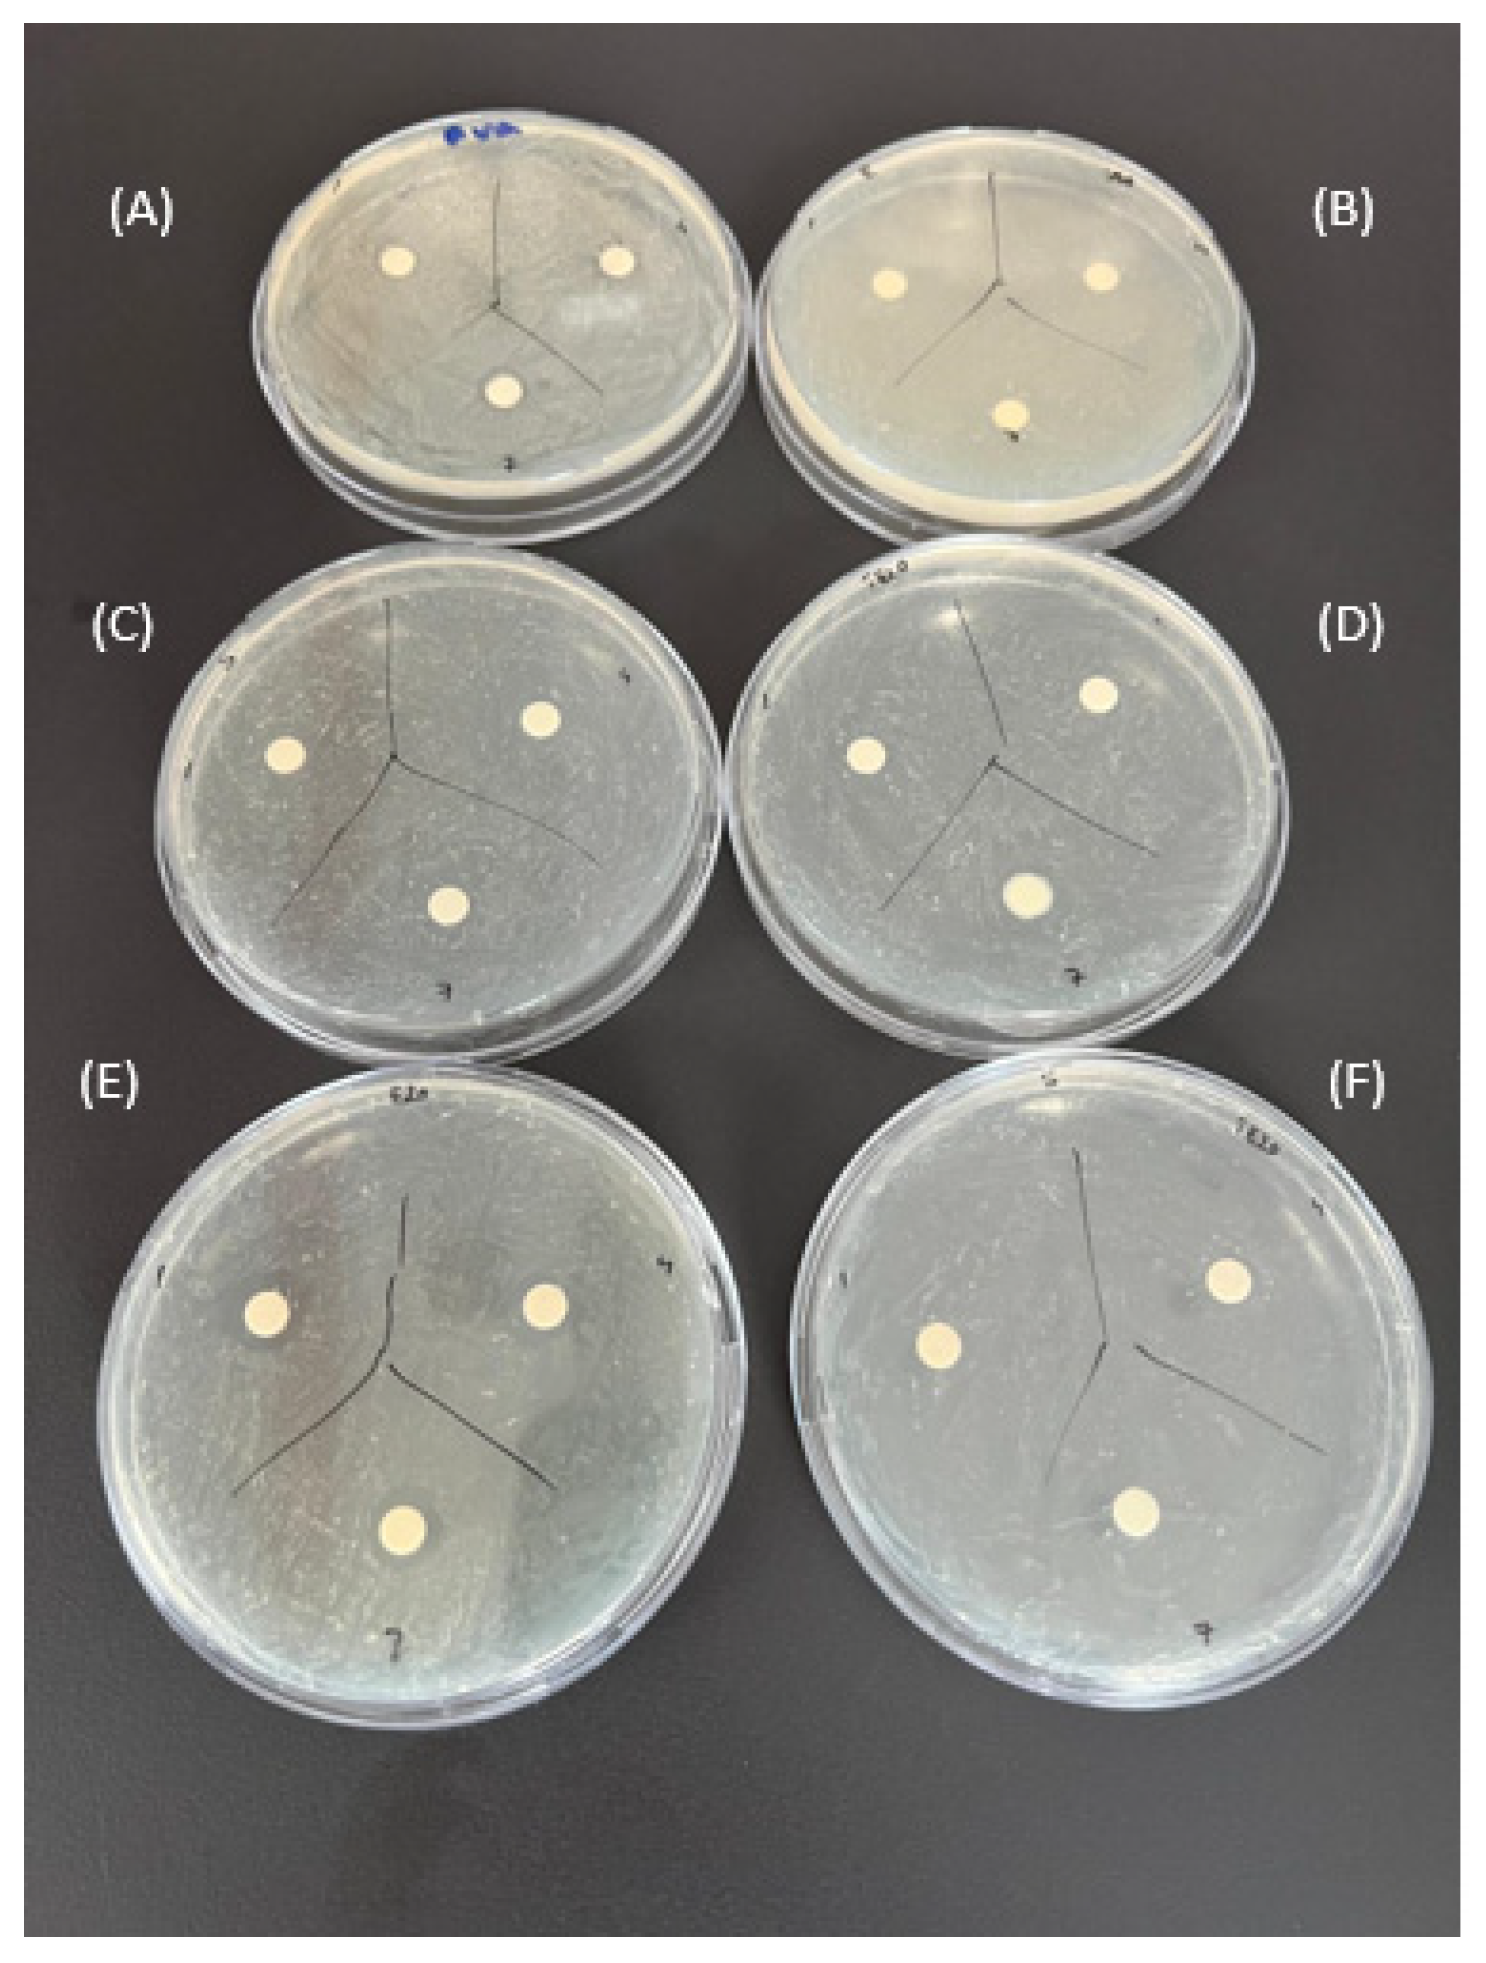

Ibuprofen-Loaded Silver Nanoparticle-Doped PVA Gels: Green Synthesis, In Vitro Cytotoxicity, and Antibacterial Analyses
Abstract
1. Introduction
2. Result and Discussions
2.1. Characterization of AgNPs
2.2. Characterization of the PVA Hydrogel Films
2.2.1. FT-IR Spectroscopy
2.2.2. Swelling Test
2.2.3. Mechanical Test
2.2.4. SEM Results
2.2.5. Cumulative Release of Ibuprofen
2.3. Determination of Cell Viability by In Vitro Cytotoxicity Analysis
2.4. Comparison of the Antibacterial Effects of Hydrogel Films
3. Conclusions
4. Materials and Methods
4.1. Solution Preparation
4.1.1. Preparation of Ibuprofen Stock Solution
4.1.2. Preparation of PVA Solutions
4.1.3. Extraction of Plant Extract and Green Synthesis of AgNPs
4.1.4. Preparation of AgNP-doped PVA Solutions
4.2. Characterization
4.2.1. Particle Size Analysis
4.2.2. UV–Vis Absorption Spectroscopy
4.2.3. FT-IR Spectroscopy
4.2.4. Swelling Test
4.2.5. Mechanical Test
4.2.6. SEM Analysis
4.2.7. Loading and Release Studies of Ibuprofen in PVA Hydrogels
4.3. In Vitro Cytotoxicity Analysis
4.4. Antibacterial Activity Test
Author Contributions
Funding
Data Availability Statement
Acknowledgments
Conflicts of Interest
References
- Adepu, S.; Ramakrishna, S. Controlled Drug Delivery Systems: Current Status and Future Directions. Molecules 2021, 26, 5905. [Google Scholar] [CrossRef]
- Khizar, S.; Alrushaid, N.; Alam Khan, F.; Zine, N.; Jaffrezic-Renault, N.; Errachid, A.; Elaissari, A. Nanocarriers Based Novel and Effective Drug Delivery System. Int. J. Pharm. 2023, 632, 122570. [Google Scholar] [CrossRef]
- Lee, J.W.; Park, R.J.H. Bioadhesive-Based Dosage Forms: The next Generation. J. Pharm. Sci. 2000, 89, 850–866. [Google Scholar] [CrossRef]
- Anand, V.P. Biocompatibility Safety Assessment of Devices: FDA/ISO and Japanese Guide. Med. DevicesDiagnostic Ind. Mag. 2000, 22, 206–219. [Google Scholar]
- Rambhia, K.J.; Ma, P.X. Controlled Drug Release for Tissue Engineering. J. Control. Release 2015, 219, 119–128. [Google Scholar] [CrossRef] [PubMed]
- Baker, M.I.; Walsh, S.P.; Schwartz, Z.; Boyan, B.D. A Review of Polyvinyl Alcohol and Its Uses in Cartilage and Orthopedic Applications. J. Biomed. Mater. Res. B Appl. Biomater. 2012, 100B, 1451–1457. [Google Scholar] [CrossRef] [PubMed]
- Zhang, W.; Dai, L.; Sun, T.; Qin, C.; Wang, J.; Sun, J.; Dai, L. A Transparent, Self-Adhesive and Fully Recyclable Conductive PVA Based Hydrogel for Wearable Strain Sensor. Polymer 2023, 283, 126281. [Google Scholar] [CrossRef]
- Huang, J.; Wu, C.; Yu, X.; Li, H.; Ding, S.; Zhang, W. Biocompatible Autonomic Self-Healing PVA-TA Hydrogel with High Mechanical Strength. Macromol. Chem. Phys. 2021, 222, 2100061. [Google Scholar] [CrossRef]
- Jiang, S.; Liu, S.; Feng, W. PVA Hydrogel Properties for Biomedical Application. J. Mech. Behav. Biomed. Mater. 2011, 4, 1228–1233. [Google Scholar] [CrossRef] [PubMed]
- Kesharwani, P.; Bisht, A.; Alexander, A.; Dave, V.; Sharma, S. Biomedical Applications of Hydrogels in Drug Delivery System: An Update. J. Drug Deliv. Sci. Technol. 2021, 66, 102914. [Google Scholar] [CrossRef]
- Hanna, J.R.; Giacopelli, J.A. A Review of Wound Healing and Wound Dressing Products. J. Foot Ankle Surg. 1997, 36, 2–14. [Google Scholar] [CrossRef] [PubMed]
- Ying, S.; Guan, Z.; Ofoegbu, P.C.; Clubb, P.; Rico, C.; He, F.; Hong, J. Green Synthesis of Nanoparticles: Current Developments and Limitations. Environ. Technol. Innov. 2022, 26, 102336. [Google Scholar] [CrossRef]
- Dikshit, P.K.; Kumar, J.; Das, A.K.; Sadhu, S.; Sharma, S.; Singh, S.; Gupta, P.K.; Kim, B.S. Green Synthesis of Metallic Nanoparticles: Applications and Limitations. Catalysts 2021, 11, 902. [Google Scholar] [CrossRef]
- Sureshkumar, J.; Jenipher, C.; Sriramavaratharajan, V.; Gurav, S.S.; Gandhi, G.R.; Ravichandran, K.; Ayyanar, M. Genus Equisetum L: Taxonomy, Toxicology, Phytochemistry and Pharmacology. J. Ethnopharmacol. 2023, 314, 116630. [Google Scholar] [CrossRef] [PubMed]
- Yeganegi, M.; Tabatabaei Yazdi, F.; Mortazavi, S.A.; Asili, J.; Alizadeh Behbahani, B.; Beigbabaei, A. Equisetum Telmateia Extracts: Chemical Compositions, Antioxidant Activity and Antimicrobial Effect on the Growth of Some Pathogenic Strain Causing Poisoning and Infection. Microb. Pathog. 2018, 116, 62–67. [Google Scholar] [CrossRef] [PubMed]
- Stajner, D.; Popović, B.M.; Canadanović-Brunet, J.; Anackov, G. Exploring Equisetum arvense L., Equisetum ramosissimum L. and Equisetum telmateia L. as Sources of Natural Antioxidants. Phytother. Res. PTR 2009, 23, 546–550. [Google Scholar] [CrossRef]
- Radojevic, I.D.; Stankovic, M.S.; Stefanovic, O.D.; Topuzovic, M.D.; Comic, L.R.; Ostojic, A.M. Great Horsetail (Equisetum Telmateia Ehrh.): Active Substances Content and Biological Effects. EXCLI J. 2012, 11, 59–67. [Google Scholar]
- Batir-Marin, D.; Mircea, C.; Boev, M.; Burlec, A.F.; Corciova, A.; Fifere, A.; Iacobescu, A.; Cioanca, O.; Verestiuc, L.; Hancianu, M. In Vitro Antioxidant, Antitumor and Photocatalytic Activities of Silver Nanoparticles Synthesized Using Equisetum Species: A Green Approach. Molecules 2021, 26, 7325. [Google Scholar] [CrossRef]
- Morgado, P.I.; Miguel, S.P.; Correia, I.J.; Aguiar-Ricardo, A. Ibuprofen Loaded PVA/Chitosan Membranes: A Highly Efficient Strategy towards an Improved Skin Wound Healing. Carbohydr. Polym. 2017, 159, 136–145. [Google Scholar] [CrossRef]
- Rainsford, K.D. Ibuprofen: Pharmacology, Efficacy and Safety. Inflammopharmacology 2009, 17, 275–342. [Google Scholar] [CrossRef]
- Kantor, T.G. Ibuprofen. Ann. Intern. Med. 1979, 91, 877. [Google Scholar] [CrossRef]
- Chen, T.; He, X.; Jiang, T.; Liu, W.; Li, Y.; Liu, P.; Liu, Z. Synthesis and Drug Delivery Properties of Ibuprofen-Cellulose Nanofibril System. Int. J. Biol. Macromol. 2021, 182, 931–937. [Google Scholar] [CrossRef]
- Li, L.; Xie, C.; Xiao, X. Polydopamine Modified TiO2 Nanotube Arrays as a Local Drug Delivery System for Ibuprofen. J. Drug Deliv. Sci. Technol. 2020, 56, 101537. [Google Scholar] [CrossRef]
- Bensouiki, S.; Belaib, F.; Sindt, M.; Magri, P.; Rup-Jacques, S.; Bensouici, C.; Meniai, A.-H. Evaluation of Anti-Inflammatory Activity and In Vitro Drug Release of Ibuprofen-Loaded Nanoparticles Based on Sodium Alginate and Chitosan. Arab. J. Sci. Eng. 2020, 45, 7599–7609. [Google Scholar] [CrossRef]
- Ávila, M.I.; Alonso-Morales, N.; Baeza, J.A.; Rodríguez, J.J.; Gilarranz, M.A. High Load Drug Release Systems Based on Carbon Porous Nanocapsule Carriers. Ibuprofen Case Study. J. Mater. Chem. B 2020, 8, 5293–5304. [Google Scholar] [CrossRef] [PubMed]
- de Lima, A.F.; Pegorin, G.S.; Miranda, M.C.R.; Cachaneski-Lopes, J.P.; de Silva, W.M.; Borges, F.A.; Guerra, N.B.; Herculano, R.D.; Batagin-Neto, A. Ibuprofen-Loaded Biocompatible Latex Membrane for Drug Release: Characterization and Molecular Modeling. J. Appl. Biomater. Funct. Mater. 2021, 19, 22808000211005383. [Google Scholar] [CrossRef]
- Dash, A.K.; ve Cudworth, G.C., II. Therapeutic Applications of Implantable Drug Delivery Systems. J. Pharmacol. Toxicol. Methods 1998, 40, 1–12. [Google Scholar] [CrossRef] [PubMed]
- Moreno-Trejo, M.B.; Sánchez-Domínguez, M. Mesquite Gum as a Novel Reducing and Stabilizing Agent for Modified Tollens Synthesis of Highly Concentrated Ag Nanoparticles. Materials 2016, 9, 817. [Google Scholar] [CrossRef]
- Singh, S.; Bharti, A.; Meena, V.K. Green Synthesis of Multi-Shaped Silver Nanoparticles: Optical, Morphological and Antibacterial Properties. J. Mater. Sci. Mater. Electron. 2015, 26, 3638–3648. [Google Scholar] [CrossRef]
- Upadhyay, P.; Mishra, S.K.; Purohit, S.; Dubey, G.P.; Singh Chauhan, B.; Srikrishna, S. Antioxidant, Antimicrobial and Cytotoxic Potential of Silver Nanoparticles Synthesized Using Flavonoid Rich Alcoholic Leaves Extract of Reinwardtia Indica. Drug Chem. Toxicol. 2019, 42, 65–75. [Google Scholar] [CrossRef]
- Bueno, J.N.N.; Corradini, E.; De Souza, P.R.; Marques, V.D.S.; Radovanovic, E.; Muniz, E.C. Films Based on Mixtures of Zein, Chitosan, and PVA: Development with Perspectives for Food Packaging Application. Polym. Test. 2021, 101, 107279. [Google Scholar] [CrossRef]
- Sudhamani, S.R.; Prasad, M.S.; Udaya Sankar, K. DSC and FTIR Studies on Gellan and Polyvinyl Alcohol (PVA) Blend Films. Food Hydrocoll. 2003, 17, 245–250. [Google Scholar] [CrossRef]
- Jipa, I.M.; Stoica, A.; Stroescu, M.; Dobre, L.-M.; Dobre, T.; Jinga, S.; Tardei, C. Potassium Sorbate Release from Poly(Vinyl Alcohol)-Bacterial Cellulose Films. Chem. Pap. 2012, 66, 138–143. [Google Scholar] [CrossRef]
- Elkordy, A.A.; Essa, E.A. Dissolution of Ibuprofen from Spray Dried and Spray Chilled Particles. Pak. J. Pharm. Sci. 2010, 23, 284–290. [Google Scholar] [PubMed]
- Wahab, A.; Khan, G.M.; Akhlaq, M.; Khan, N.; Hussain, A. Pre-Formulation Investigation and in Vitro Evaluation of Directly Compressed Ibuprofen-Ethocel Oral Controlled Release Matrix Tablets: A Kinetic Approach. Afr. J. Pharm. Pharmacol. 2011, 5, 2118–2127. [Google Scholar] [CrossRef]
- Chaturvedi, A.; Bajpai, A.K.; Bajpai, J.; Singh, S.K. Evaluation of Poly (Vinyl Alcohol) Based Cryogel–Zinc Oxide Nanocomposites for Possible Applications as Wound Dressing Materials. Mater. Sci. Eng. C 2016, 65, 408–418. [Google Scholar] [CrossRef] [PubMed]
- Yadollahi, M.; Gholamali, I.; Namazi, H.; Aghazadeh, M. Synthesis and Characterization of Antibacterial Carboxymethyl Cellulose/ZnO Nanocomposite Hydrogels. Int. J. Biol. Macromol. 2015, 74, 136–141. [Google Scholar] [CrossRef]
- Ahmed, M.K.; Menazea, A.A.; Mansour, S.F.; Al-Wafi, R. Differentiation between Cellulose Acetate and Polyvinyl Alcohol Nanofibrous Scaffolds Containing Magnetite Nanoparticles/Graphene Oxide via Pulsed Laser Ablation Technique for Tissue Engineering Applications. J. Mater. Res. Technol. 2020, 9, 11629–11640. [Google Scholar] [CrossRef]
- Bhowmick, S.; Mohanty, S.; Koul, V. Fabrication of Transparent Quaternized PVA/Silver Nanocomposite Hydrogel and Its Evaluation as an Antimicrobial Patch for Wound Care Systems. J. Mater. Sci. Mater. Med. 2016, 27, 160. [Google Scholar] [CrossRef]
- Sun, L.; Wang, J.; Liang, J.; Li, G. Boric Acid Cross-Linked 3D Polyvinyl Alcohol Gel Beads by NaOH-Titration Method as a Suitable Biomass Immobilization Matrix. J. Polym. Environ. 2020, 28, 532–541. [Google Scholar] [CrossRef]
- Peppas, N.A.; Stauffer, S.R. Reinforced Uncrosslinked Poly (Vinyl Alcohol) Gels Produced by Cyclic Freezing-Thawing Processes: A Short Review. J. Control. Release 1991, 16, 305–310. [Google Scholar] [CrossRef]
- Vatanpour, V.; Teber, O.O.; Mehrabi, M.; Koyuncu, I. Polyvinyl Alcohol-Based Separation Membranes: A Comprehensive Review on Fabrication Techniques, Applications and Future Prospective. Mater. Today Chem. 2023, 28, 101381. [Google Scholar] [CrossRef]
- Kumar, A.; Behl, T.; Chadha, S. Synthesis of Physically Crosslinked PVA/Chitosan Loaded Silver Nanoparticles Hydrogels with Tunable Mechanical Properties and Antibacterial Effects. Int. J. Biol. Macromol. 2020, 149, 1262–1274. [Google Scholar] [CrossRef] [PubMed]
- Wang, C.; Shen, Z.; Hu, P.; Wang, T.; Zhang, X.; Liang, L.; Bai, J.; Qiu, L.; Lai, X.; Yang, X.; et al. Facile Fabrication and Characterization of High-Performance Borax-PVA Hydrogel. J. Sol-Gel Sci. Technol. 2022, 101, 103–113. [Google Scholar] [CrossRef]
- Trieu, H.H.; Qutubuddin, S. Polyvinyl Alcohol Hydrogels I. Microscopic Structure by Freeze-Etching and Critical Point Drying Techniques. Colloid Polym. Sci. 1994, 272, 301–309. [Google Scholar] [CrossRef]
- Nagpal, M.; Maheshwari, D.K.; Rakha, P.; Dureja, H.; Goyal, S.; Dhingra, G. Formulation Development and Evaluation of Alginate Microspheres of Ibuprofen. J. Young Pharm. 2012, 4, 13–16. [Google Scholar] [CrossRef] [PubMed]
- Khan, S.; Ranjha, N.M. Effect of Degree of Cross-Linking on Swelling and on Drug Release of Low Viscous Chitosan/Poly(Vinyl Alcohol) Hydrogels. Polym. Bull. 2014, 71, 2133–2158. [Google Scholar] [CrossRef]
- Mawad, D.; Odell, R.; Poole-Warren, L.A. Network Structure and Macromolecular Drug Release from Poly(Vinyl Alcohol) Hydrogels Fabricated via Two Crosslinking Strategies. Int. J. Pharm. 2009, 366, 31–37. [Google Scholar] [CrossRef]
- Dharmalingam, K.; Anandalakshmi, R. Fabrication, Characterization and Drug Loading Efficiency of Citric Acid Crosslinked NaCMC-HPMC Hydrogel Films for Wound Healing Drug Delivery Applications. Int. J. Biol. Macromol. 2019, 134, 815–829. [Google Scholar] [CrossRef]
- Chung, H.K.; Wongso, V.; Sambudi, N.S.; Isnaeni. Biowaste-Derived Carbon Dots/Hydroxyapatite Nanocomposite as Drug Delivery Vehicle for Acetaminophen. J. Sol-Gel Sci. Technol. 2020, 93, 214–223. [Google Scholar] [CrossRef]
- Sreedharan, S.; Singh, R. Ciprofloxacin Functionalized Biogenic Gold Nanoflowers as Nanoantibiotics Against Pathogenic Bacterial Strains. Int. J. Nanomed. 2019, 14, 9905–9916. [Google Scholar] [CrossRef]
- Xu, J.; Xu, B.; Shou, D.; Xia, X.; Hu, Y. Preparation and Evaluation of Vancomycin-Loaded N-Trimethyl Chitosan Nanoparticles. Polymers 2015, 7, 1850–1870. [Google Scholar] [CrossRef]
- Altun, E.; Yuca, E.; Ekren, N.; Kalaskar, D.M.; Ficai, D.; Dolete, G.; Ficai, A.; Gunduz, O. Kinetic Release Studies of Antibiotic Patches for Local Transdermal Delivery. Pharmaceutics 2021, 13, 613. [Google Scholar] [CrossRef]
- Abudabbus, M.M.; Jevremović, I.; Janković, A.; Perić-Grujić, A.; Matić, I.; Vukašinović-Sekulić, M.; Hui, D.; Rhee, K.Y.; Mišković-Stanković, V. Biological Activity of Electrochemically Synthesized Silver Doped Polyvinyl Alcohol/Graphene Composite Hydrogel Discs for Biomedical Applications. Compos. Part B Eng. 2016, 104, 26–34. [Google Scholar] [CrossRef]
- Leksomboon, R.; Kumpangnil, K. Ibuprofen and Diclofenac Differentially Affect Cell Viability, Apoptosis and Morphology Changes of Human Cholangiocarcinoma Cell Lines. J. Taibah Univ. Med. Sci. 2022, 17, 869–879. [Google Scholar] [CrossRef]
- Meneses, L.; Craveiro, R.; Jesus, A.R.; Reis, M.A.M.; Freitas, F.; Paiva, A. Supercritical CO2 Assisted Impregnation of Ibuprofen on Medium-Chain-Length Polyhydroxyalkanoates (Mcl-PHA). Molecules 2021, 26, 4772. [Google Scholar] [CrossRef] [PubMed]
- Swaroop, K.; Francis, S.; Somashekarappa, H.M. Gamma Irradiation Synthesis of Ag/PVA Hydrogels and Its Antibacterial Activity. Mater. Today Proc. 2016, 3, 1792–1798. [Google Scholar] [CrossRef]
- Vanlalveni, C.; Lallianrawna, S.; Biswas, A.; Selvaraj, M.; Changmai, B.; Lalthazuala Rokhum, S. Green Synthesis of Silver Nanoparticles Using Plant Extracts and Their Antimicrobial Activities: A Review of Recent Literature. RSC Adv. 2021, 11, 2804–2837. [Google Scholar] [CrossRef] [PubMed]
- Dangi, S.; Gupta, A.; Gupta, D.K.; Singh, S.; Parajuli, N. Green Synthesis of Silver Nanoparticles Using Aqueous Root Extract of Berberis Asiatica and Evaluation of Their Antibacterial Activity. Chem. Data Collect. 2020, 28, 100411. [Google Scholar] [CrossRef]
- Bhowmick, S.; Koul, V. Assessment of PVA/Silver Nanocomposite Hydrogel Patch as Antimicrobial Dressing Scaffold: Synthesis, Characterization and Biological Evaluation. Mater. Sci. Eng. C 2016, 59, 109–119. [Google Scholar] [CrossRef]
- Mourdikoudis, S.R.M. Pallares, and N.T. Thanh, Characterization Techniques for Nanoparticles: Comparison and Complementarity upon. Stud. Nanoparticle Properties. Nanoscale 2018, 10, 12871–12934. [Google Scholar]
- Byun, H.; Hong, B.; Nam, S.Y.; Jung, S.Y.; Rhim, J.W.; Lee, S.B.; Moon, G.Y. Swelling Behavior and Drug Release of Poly(Vinyl Alcohol) Hydrogel Cross-Linked with Poly(Acrylic Acid). Macromol. Res. 2008, 16, 189–193. [Google Scholar] [CrossRef]
- Saifullah, Q.; Sharma, A.; Kabra, A.; Alshammari, A.; Albekairi, T.H.; Alharbi, M.; Abdalla, M. Development and Optimization of Film Forming Non-Pressurized Liquid Bandage for Wound Healing by Box-Behnken Statistical Design. Saudi Pharm. J. 2023, 31, 101864. [Google Scholar] [CrossRef] [PubMed]
- Gottimukkala, K.S.V.; Harika, R.P.; Zamare, D. Green Synthesis of Iron Nanoparticles Using Green Tea Leaves Extract. J. Nanomed. Biother. Discov. 2017, 7, 151. [Google Scholar]
- Mossman, T. Rapid Colorimetric Assay for Cellular Growth and Survival: Application to Proliferation and Cytotoxicity Assays. J. Immunol. Methods 1983, 65, 55–63. [Google Scholar] [CrossRef]
- Gholipour, K.A.; Bahrami, S.H.; Nouri, M. Chitosan-Poly(Vinyl Alcohol) Blend Nanofibers: Morphology, Biological and Antimicrobial Properties. E-Polym. 2009, 9, 133. [Google Scholar] [CrossRef]
- Agustin, Y.E.; Padmawijaya, K.S. Effect of Glycerol and Zinc Oxide Addition on Antibacterial Activity of Biodegradable Bioplastics from Chitosan-Kepok Banana Peel Starch. IOP Conf. Ser. Mater. Sci. Eng. 2017, 223, 012046. [Google Scholar] [CrossRef]

| Kinetic Model | R2 | ||
|---|---|---|---|
| Equation | B1 | E1 | |
| Zero-order | Qt = Q0 + K0 t | 0.9194 | 0.6819 |
| First order | ln Qt = ln Q0 + K1 t | 0.9239 | 0.9382 |
| Higuchi | Qt = KH t 1/2 | 0.9424 | 0.8313 |
| Korsmeyer-pepas | Qt /Q∞ = Kktn | 0.9504 | 0.9612 |
| Code | PVA (g) | PBS (mL) | AgNPs (mg) |
|---|---|---|---|
| B1 | 0.5 | 10 | 1 |
| B2 | 0.5 | 10 | - |
| E1 | 1 | 10 | 1 |
| E2 | 1 | 10 | - |
Disclaimer/Publisher’s Note: The statements, opinions and data contained in all publications are solely those of the individual author(s) and contributor(s) and not of MDPI and/or the editor(s). MDPI and/or the editor(s) disclaim responsibility for any injury to people or property resulting from any ideas, methods, instructions or products referred to in the content. |
© 2024 by the authors. Licensee MDPI, Basel, Switzerland. This article is an open access article distributed under the terms and conditions of the Creative Commons Attribution (CC BY) license (https://creativecommons.org/licenses/by/4.0/).
Share and Cite
Altınay, E.; Köse, F.Z.; Ateş, S.C.; Kızılbey, K. Ibuprofen-Loaded Silver Nanoparticle-Doped PVA Gels: Green Synthesis, In Vitro Cytotoxicity, and Antibacterial Analyses. Gels 2024, 10, 143. https://doi.org/10.3390/gels10020143
Altınay E, Köse FZ, Ateş SC, Kızılbey K. Ibuprofen-Loaded Silver Nanoparticle-Doped PVA Gels: Green Synthesis, In Vitro Cytotoxicity, and Antibacterial Analyses. Gels. 2024; 10(2):143. https://doi.org/10.3390/gels10020143
Chicago/Turabian StyleAltınay, Ezgi, Fatma Zehra Köse, Sezen Canım Ateş, and Kadriye Kızılbey. 2024. "Ibuprofen-Loaded Silver Nanoparticle-Doped PVA Gels: Green Synthesis, In Vitro Cytotoxicity, and Antibacterial Analyses" Gels 10, no. 2: 143. https://doi.org/10.3390/gels10020143
APA StyleAltınay, E., Köse, F. Z., Ateş, S. C., & Kızılbey, K. (2024). Ibuprofen-Loaded Silver Nanoparticle-Doped PVA Gels: Green Synthesis, In Vitro Cytotoxicity, and Antibacterial Analyses. Gels, 10(2), 143. https://doi.org/10.3390/gels10020143

